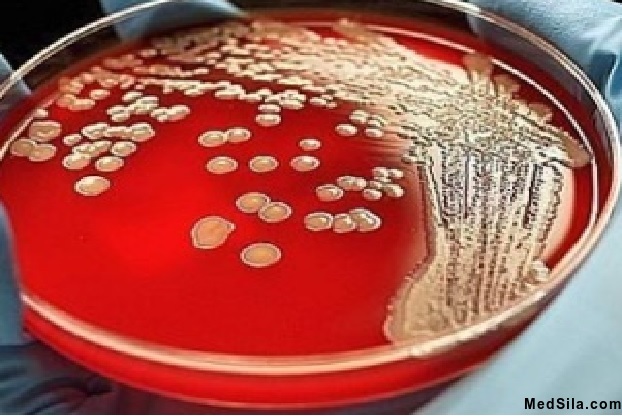
Рост бактерий на питательной среде

Определение
Посев мочи на стерильность – достаточно часто проводимый в бактериологических лабораториях анализ. Целесообразно проводить посев мочи в тех случаях, когда есть отклонения в других видах исследований мочи. Например, при повышенном содержаний лейкоцитов в общем анализе мочи, при увеличенном содержании клеточных элементов в анализе мочи по Нечипоренко. Так же необходимо сдать данный анализ при соответствующей клинической картине: при нарушении мочеиспускания, при болях при мочеиспускании; при болях внизу живота, ближе к лобку, а также в районе поясницы; при изменениях в общем анализе мочи. Именно этот анализ используют для контроля лечения антибиотиками, для определения чувствительности к лекарственным средствам организмов (микробов).
Подготовка пациента
Для начала необходимо позаботиться о емкости для сбора анализа. Стерильную баночку лучше всего приобрести в аптеке. Затем следует провести тщательный туалет промежности без использования мыла, геля для душа (так как средства интимной гигиены могут уничтожить бактерии, которых должен выявить посев). Для анализа берется средняя порция мочи, при условии отсутствия менструации на момент сдачи анализа; отказа от употребления в пищу «красящих» продуктов – свекла, морковь за несколько дней до анализа; отмены приема антибиотиков; избегать тяжелых физических нагрузок. Собранную мочу для посева (примерно 10 – 15 мл) нужно доставить в лабораторию в самый короткий срок. Следует отметить, что для детей правила сбора мочи будут такие же, как и для взрослых. Однако, у грудных детей, со сбором мочи могут возникнуть трудности, но следует помнить, что нельзя использовать пеленки, подгузники и горшок для сбора мочи.
Проведение анализа
Вовремя доставленную мочу фельдшер – лаборант регистрирует в журнале. Затем, с помощью бактериальной петли, берет небольшую каплю мочи и сеет на питательную среду (особая субстанция в чашке Петри (лабораторная посуда), которая является «едой» и оптимальной средой обитания для микроорганизмов). После чашку Петри ставят в термостат (специальный прибор, который может длительно поддерживать заданную температуру). На протяжении 10 дней фиксируют рост микроорганизмов.
Норма
Полученные результаты может расшифровывать только врач – клиницист. При этом выдачу результатов контролирует врач лабораторной диагностики. Поскольку моча в норме стерильна, то роста бактерий в чашке Петри быть не должно (это будет означать отрицательный результат).
Если бактерии выявились в минимальном количестве 1⋅ 103 КОЕ/мл – то можно сказать, что могло произойти случайное попадание бактерий с поверхности тела.
1⋅ 104 КОЕ/мл – результат сомнительный и лучше анализ повторить.
1⋅ 105 КОЕ/мл – результат при котором необходимо начинать лечение.
При получении положительных результатов врач лабораторной диагностики четко определяет вид бактерии, затем определяет чувствительность (восприимчивость) бактерии к использующимся антибиотикам.






